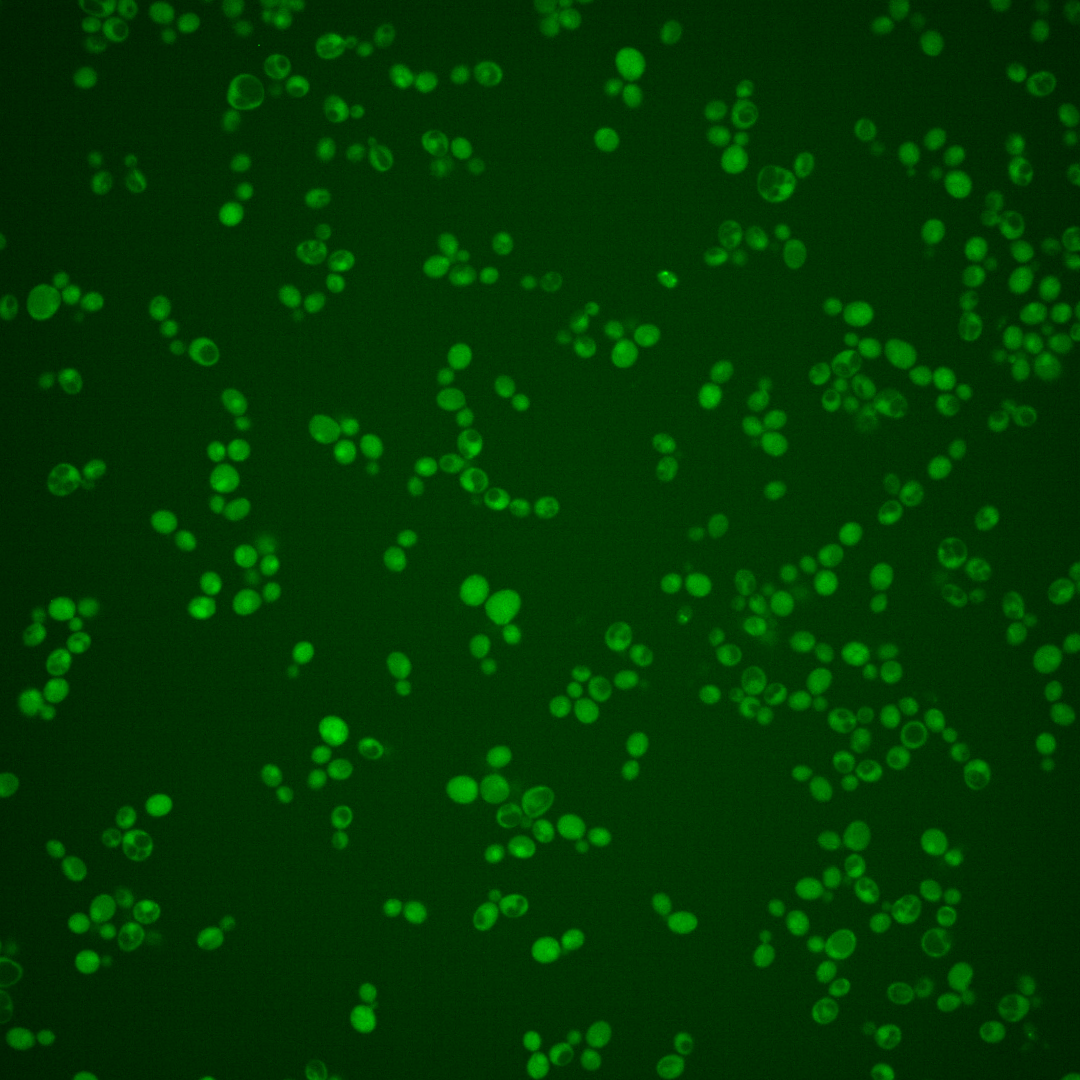
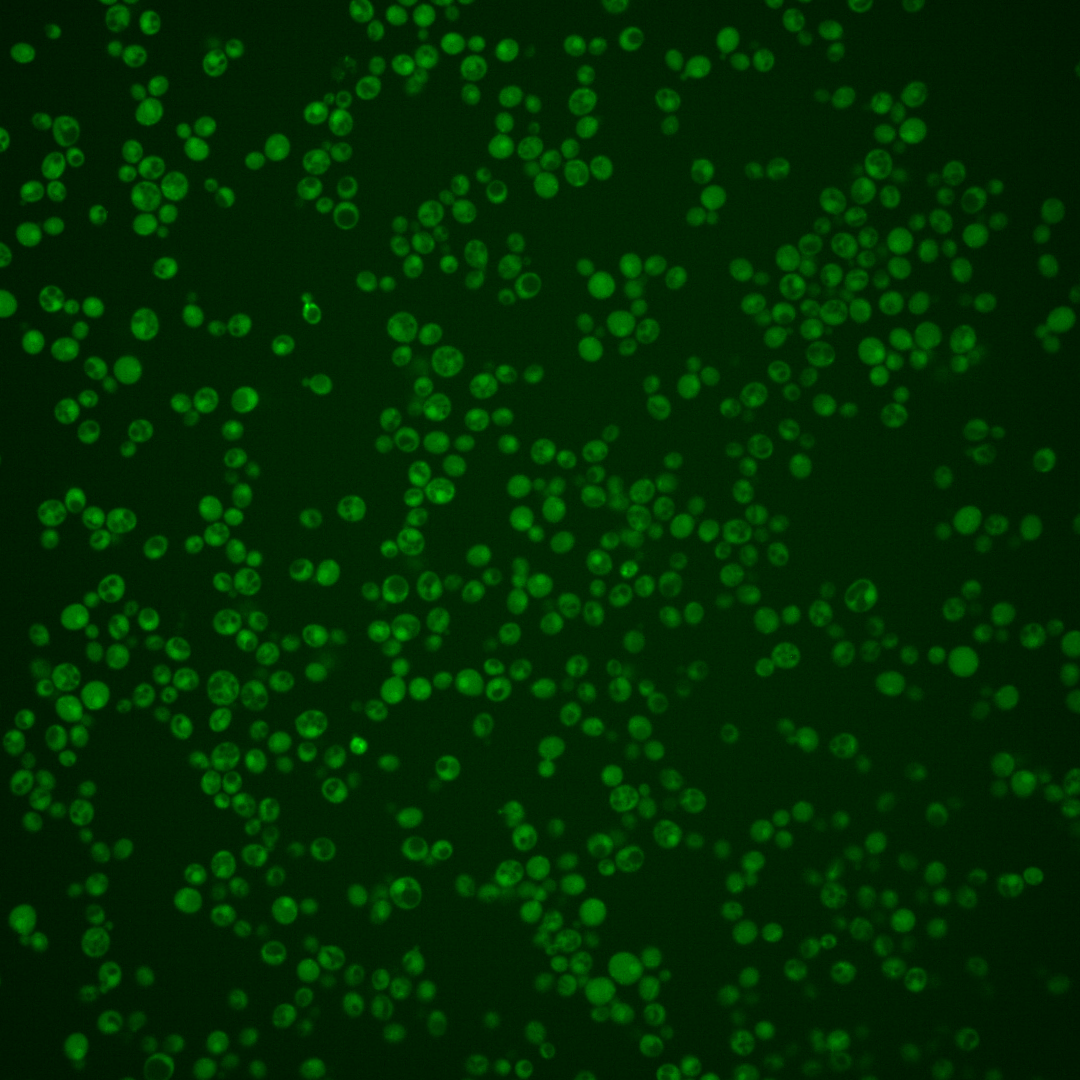
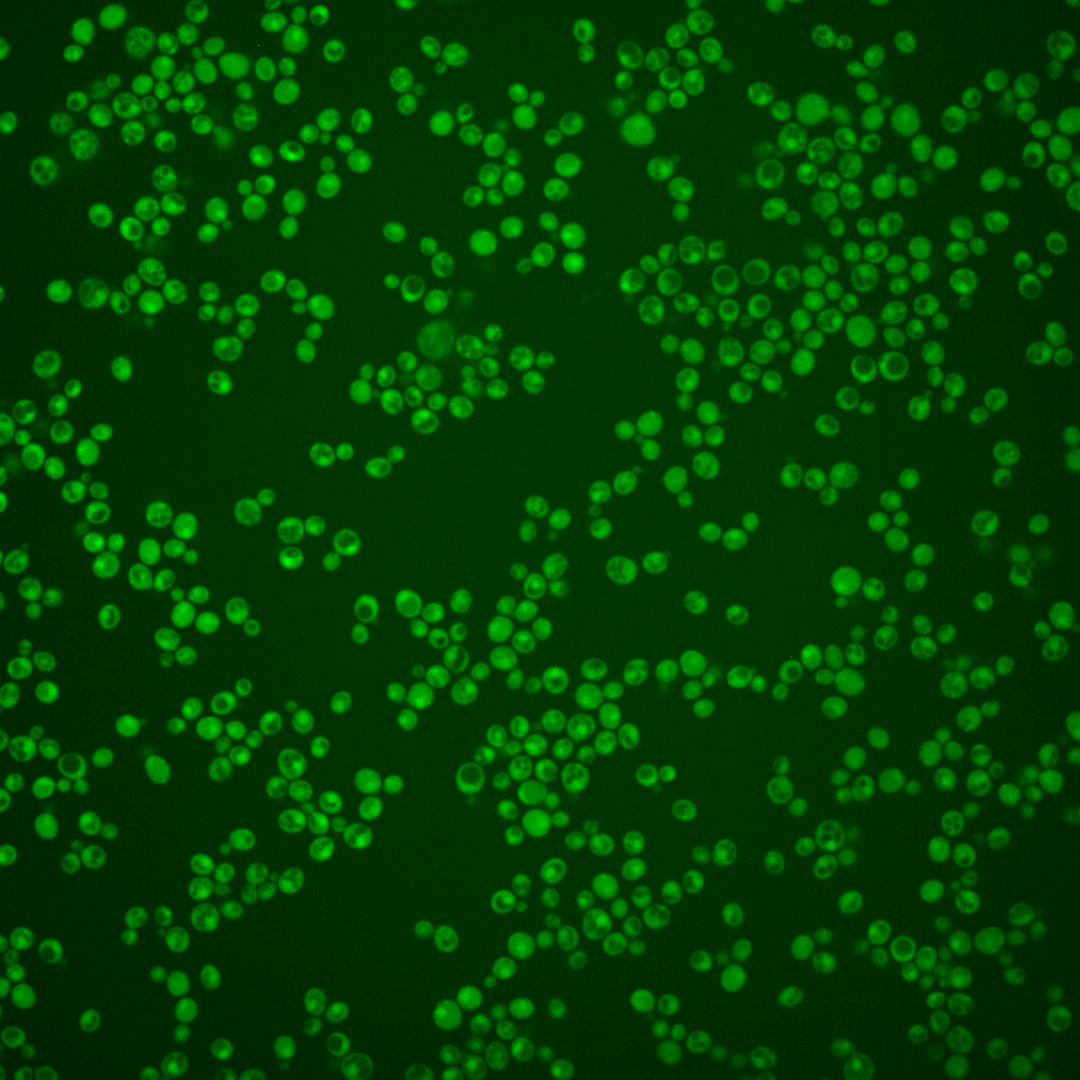
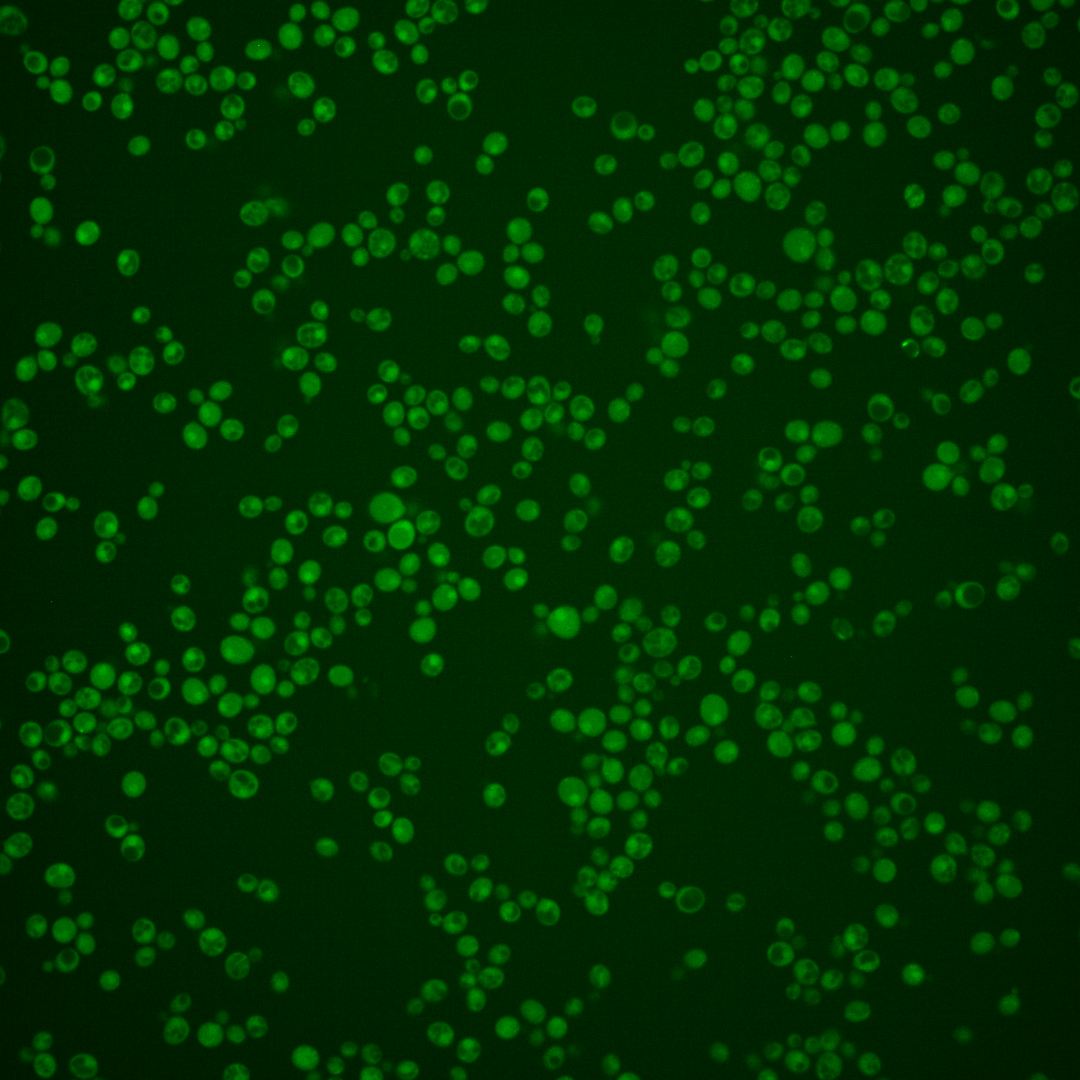
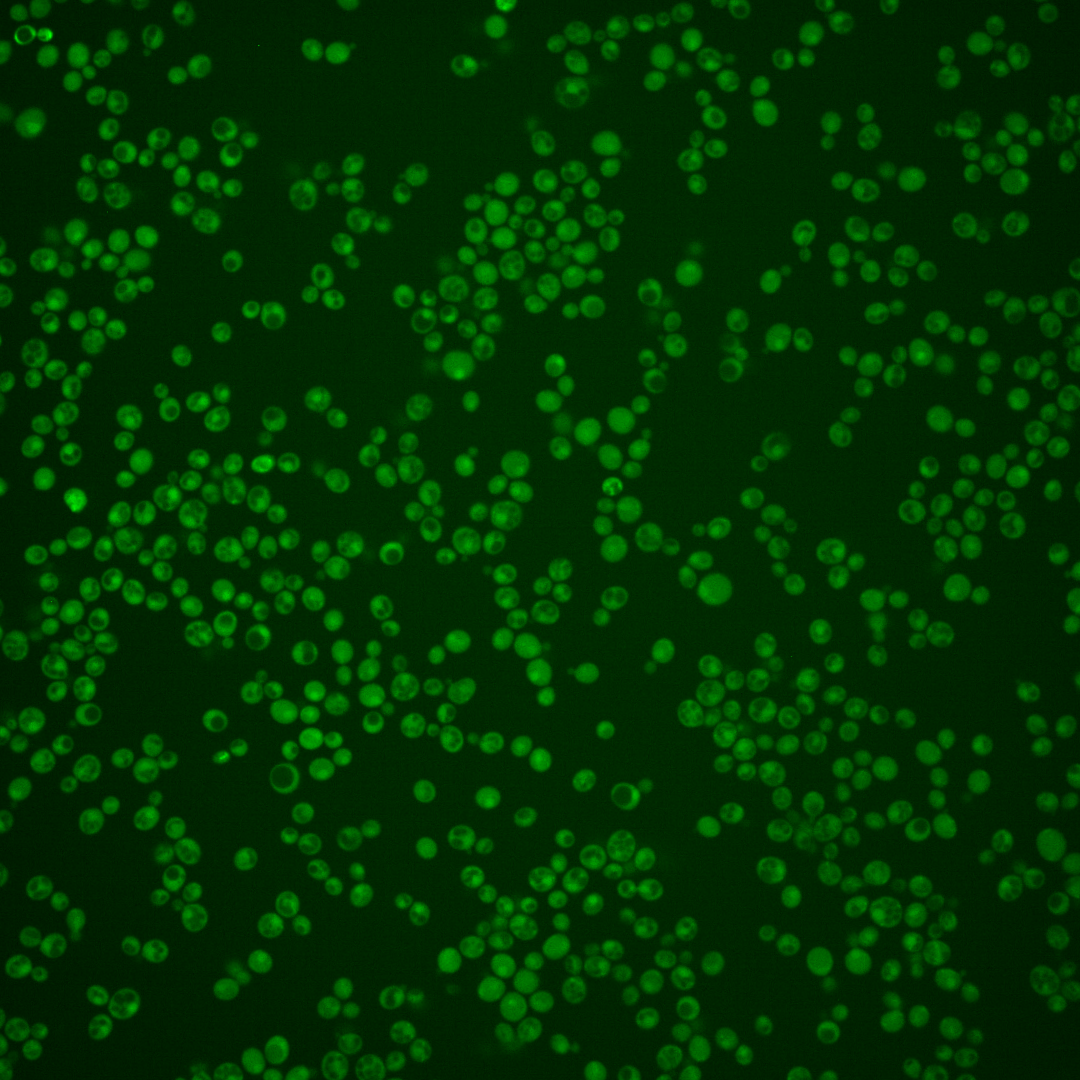

| ORF | |
|---|---|
| Human Ortholog | |
| Description | F-box protein subunit of SCF ubiquitin ligase complex; substrate-specific adaptor subunit that recruits substrates to a core ubiquitination complex |
Micrographs




















































































Sub-cellular Localization
Yeast GFP Assignment
Protein Abundance
Localization Change
External localization resources
| ensLOC | DeepLoc | |||||||||||||||||||||||
|---|---|---|---|---|---|---|---|---|---|---|---|---|---|---|---|---|---|---|---|---|---|---|---|---|
| Localization | WT1 | WT2 | WT3 | RAP60 | RAP140 | RAP220 | RAP300 | RAP380 | RAP460 | RAP540 | RAP620 | RAP700 | HU80 | HU120 | HU160 | rpd3Δ_1 | rpd3Δ_2 | rpd3Δ_3 | WT1 | WT2 | WT3 | AF100 | AF140 | AF180 |
| Cortical Patches | 1 | 0 | 0 | 1 | 0 | 0 | 0 | 1 | 0 | 0 | 1 | 0 | 0 | 0 | 0 | 0 | 0 | 0 | 1 | 1 | 1 | 0 | 1 | 3 |
| Bud | 1 | 0 | 0 | 1 | 0 | 1 | 1 | 5 | 3 | 4 | 10 | 2 | 1 | 1 | 0 | 0 | 0 | 0 | 0 | 0 | 0 | 0 | 2 | 6 |
| Bud Neck | 0 | 1 | 2 | 5 | 11 | 3 | 10 | 20 | 11 | 19 | 5 | 7 | 0 | 0 | 1 | 2 | 3 | 0 | 2 | 0 | 0 | 0 | 1 | 2 |
| Bud Site | 0 | 0 | 0 | 0 | 0 | 0 | 0 | 0 | 0 | 1 | 0 | 0 | 0 | 0 | 0 | 0 | 0 | 0 | – | – | – | – | – | – |
| Cell Periphery | 0 | 0 | 0 | 6 | 1 | 1 | 4 | 1 | 3 | 2 | 0 | 0 | 0 | 0 | 1 | 5 | 9 | 7 | 0 | 0 | 0 | 0 | 0 | 0 |
| Cytoplasm | 146 | 281 | 53 | 225 | 330 | 340 | 538 | 658 | 319 | 368 | 334 | 433 | 158 | 377 | 451 | 251 | 341 | 334 | 117 | 182 | 47 | 51 | 129 | 184 |
| Endoplasmic Reticulum | 3 | 3 | 0 | 1 | 0 | 0 | 3 | 0 | 0 | 1 | 2 | 1 | 0 | 3 | 0 | 17 | 27 | 32 | 2 | 1 | 0 | 1 | 0 | 1 |
| Endosome | 0 | 0 | 0 | 0 | 0 | 0 | 3 | 4 | 4 | 2 | 0 | 4 | 0 | 4 | 3 | 3 | 3 | 4 | 8 | 3 | 1 | 0 | 1 | 3 |
| Golgi | 0 | 1 | 0 | 0 | 0 | 0 | 0 | 1 | 0 | 0 | 0 | 0 | 0 | 0 | 0 | 1 | 4 | 1 | 0 | 1 | 0 | 0 | 0 | 1 |
| Mitochondria | 19 | 5 | 0 | 2 | 0 | 13 | 25 | 24 | 61 | 54 | 149 | 86 | 1 | 0 | 3 | 1 | 6 | 2 | 18 | 21 | 6 | 3 | 5 | 9 |
| Nucleus | 0 | 0 | 0 | 1 | 0 | 4 | 4 | 6 | 3 | 4 | 4 | 1 | 0 | 5 | 2 | 2 | 4 | 4 | 0 | 2 | 0 | 1 | 0 | 0 |
| Nuclear Periphery | 1 | 0 | 0 | 1 | 0 | 1 | 0 | 1 | 0 | 0 | 0 | 2 | 0 | 0 | 0 | 1 | 1 | 0 | 0 | 0 | 0 | 0 | 0 | 0 |
| Nucleolus | 0 | 0 | 0 | 0 | 0 | 0 | 0 | 1 | 0 | 1 | 1 | 1 | 0 | 0 | 0 | 0 | 0 | 0 | 0 | 0 | 0 | 0 | 0 | 0 |
| Peroxisomes | 0 | 0 | 0 | 0 | 0 | 0 | 0 | 0 | 0 | 0 | 0 | 1 | 0 | 0 | 0 | 0 | 1 | 1 | 0 | 0 | 0 | 0 | 0 | 0 |
| SpindlePole | 1 | 0 | 0 | 1 | 5 | 5 | 11 | 15 | 5 | 12 | 6 | 19 | 0 | 0 | 1 | 0 | 1 | 1 | 1 | 2 | 1 | 0 | 1 | 1 |
| Vac/Vac Membrane | 3 | 9 | 3 | 4 | 9 | 18 | 24 | 20 | 25 | 31 | 10 | 32 | 3 | 7 | 34 | 53 | 71 | 66 | 17 | 82 | 25 | 17 | 29 | 51 |
| Unique Cell Count | 161 | 295 | 56 | 235 | 346 | 367 | 584 | 721 | 381 | 434 | 439 | 536 | 161 | 388 | 475 | 298 | 396 | 391 | 176 | 305 | 88 | 79 | 179 | 272 |
| Labelled Cell Count | 175 | 300 | 58 | 248 | 356 | 386 | 623 | 757 | 434 | 499 | 522 | 589 | 163 | 397 | 496 | 336 | 471 | 452 | 176 | 305 | 88 | 79 | 179 | 272 |
Yeast GFP Assignment
Protein Abundance
| Screen | WT1 | WT2 | WT3 | RAP60 | RAP140 | RAP220 | RAP300 | RAP380 | RAP460 | RAP540 | RAP620 | RAP700 | HU80 | HU120 | HU160 | rpd3Δ_1 | rpd3Δ_2 | rpd3Δ_3 | AF100 | AF140 | AF180 |
|---|---|---|---|---|---|---|---|---|---|---|---|---|---|---|---|---|---|---|---|---|---|
| Mean Cell GFP Intensity (1e-4) | 3.4 | 4.2 | 5.3 | 4.8 | 5.2 | 4.4 | 4.5 | 4.8 | 4.0 | 4.0 | 3.8 | 4.0 | 5.3 | 5.2 | 5.2 | 5.9 | 5.7 | 5.6 | 5.2 | 5.4 | 5.4 |
| Std Deviation (1e-4) | 0.7 | 0.7 | 0.8 | 1.0 | 1.3 | 1.2 | 1.3 | 1.5 | 1.4 | 1.1 | 1.4 | 1.1 | 1.4 | 1.3 | 1.7 | 1.3 | 1.4 | 1.5 | 1.9 | 1.9 | 1.8 |
| Intensity Change (Log2) | – | – | – | -0.12 | -0.01 | -0.25 | -0.23 | -0.13 | -0.39 | -0.39 | -0.48 | -0.4 | 0.0 | -0.01 | -0.03 | 0.16 | 0.11 | 0.09 | -0.02 | 0.05 | 0.04 |
Localization Change
| Localization | RAP60 | RAP140 | RAP220 | RAP300 | RAP380 | RAP460 | RAP540 | RAP620 | RAP700 | HU80 | HU120 | HU160 | rpd3Δ_1 | rpd3Δ_2 | rpd3Δ_3 |
|---|---|---|---|---|---|---|---|---|---|---|---|---|---|---|---|
| Actin | – | – | – | – | – | – | – | – | – | – | – | – | – | – | – |
| Bud | – | – | – | – | – | – | – | – | – | – | – | – | 0 | 0 | 0 |
| Bud Neck | – | – | – | – | – | – | – | – | – | – | – | – | 0 | 0 | 0 |
| Bud Site | – | – | – | – | – | – | – | – | – | – | – | – | 0 | 0 | 0 |
| Cell Periphery | – | – | – | – | – | – | – | – | – | – | – | – | 0 | 0 | 0 |
| Cyto | – | – | – | – | – | – | – | – | – | – | – | – | – | – | – |
| Endoplasmic Reticulum | – | – | – | – | – | – | – | – | – | – | – | – | 0 | 0 | 0 |
| Endosome | – | – | – | – | – | – | – | – | – | – | – | – | 0 | 0 | 0 |
| Golgi | – | – | – | – | – | – | – | – | – | – | – | – | 0 | 0 | 0 |
| Mitochondria | – | – | – | – | – | – | – | – | – | – | – | – | 0 | 0 | 0 |
| Nuclear Periphery | – | – | – | – | – | – | – | – | – | – | – | – | 0 | 0 | 0 |
| Nuc | – | – | – | – | – | – | – | – | – | – | – | – | – | – | – |
| Nucleolus | – | – | – | – | – | – | – | – | – | – | – | – | 0 | 0 | 0 |
| Peroxisomes | – | – | – | – | – | – | – | – | – | – | – | – | 0 | 0 | 0 |
| SpindlePole | – | – | – | – | – | – | – | – | – | – | – | – | 0 | 0 | 0 |
| Vac | – | – | – | – | – | – | – | – | – | – | – | – | – | – | – |
| Cortical Patches | – | – | – | – | – | – | – | – | – | – | – | – | 0 | 0 | 0 |
| Cytoplasm | – | – | – | – | – | – | – | – | – | – | – | – | 0 | 0 | 0 |
| Nucleus | – | – | – | – | – | – | – | – | – | – | – | – | 0 | 0 | 0 |
| Vacuole | – | – | – | – | – | – | – | – | – | – | – | – | 2.3 | 2.4 | 2.2 |
External localization resources
Images






























Protein Concentration and Protein Localization Data
| R1 | R2 | R3 | ||||||||||||||||
|---|---|---|---|---|---|---|---|---|---|---|---|---|---|---|---|---|---|---|
| G1 Pre-START | G1 Post-START | S/G2 | Metaphase | Anaphase | Telophase | G1 Pre-START | G1 Post-START | S/G2 | Metaphase | Anaphase | Telophase | G1 Pre-START | G1 Post-START | S/G2 | Metaphase | Anaphase | Telophase | |
| Concentration | -0.2429 | -0.301 | -0.0085 | -0.6823 | -0.1687 | -0.3878 | -0.8414 | -0.2992 | -0.1115 | -0.2979 | -0.2169 | -0.1545 | -1.6143 | -1.4051 | -1.5058 | -1.6015 | -1.4055 | -1.1182 |
| Actin | 0.0057 | 0.0002 | 0.0144 | 0.0001 | 0.0436 | 0.0155 | 0.0169 | 0.0004 | 0.0152 | 0.0044 | 0.0002 | 0.0004 | 0.0088 | 0.0004 | 0.0368 | 0.0001 | 0.0102 | 0.0006 |
| Bud | 0.0015 | 0.0026 | 0.0006 | 0.0018 | 0.0133 | 0.0001 | 0.0005 | 0.0008 | 0.0031 | 0.0004 | 0.0001 | 0.0009 | 0.0196 | 0.0088 | 0.0006 | 0.0005 | 0.0002 | 0.0001 |
| Bud Neck | 0.0036 | 0 | 0.0013 | 0.0001 | 0.0018 | 0.0004 | 0.0007 | 0.0002 | 0.0007 | 0.0069 | 0.0001 | 0.0009 | 0.0002 | 0.0002 | 0.0037 | 0 | 0.0006 | 0.0007 |
| Bud Periphery | 0.0033 | 0.0027 | 0.0007 | 0.0024 | 0.0142 | 0.0001 | 0.0015 | 0.001 | 0.0017 | 0.0007 | 0.0001 | 0.0023 | 0.0074 | 0.0016 | 0.0007 | 0.0011 | 0.0003 | 0.0002 |
| Bud Site | 0.0109 | 0.0027 | 0.0062 | 0.0001 | 0.0051 | 0.0001 | 0.0048 | 0.0054 | 0.0101 | 0.0052 | 0.0003 | 0.0007 | 0.0202 | 0.0107 | 0.0124 | 0.0001 | 0.0005 | 0.0001 |
| Cell Periphery | 0.0003 | 0.0001 | 0.0003 | 0.0001 | 0.0004 | 0 | 0.0019 | 0.0002 | 0.0003 | 0.0007 | 0.0001 | 0.0003 | 0.0005 | 0.0004 | 0.0009 | 0.0001 | 0.0001 | 0.0002 |
| Cytoplasm | 0.0227 | 0.0653 | 0.0746 | 0.0454 | 0.1486 | 0.1224 | 0.0188 | 0.0555 | 0.0705 | 0.0496 | 0.0358 | 0.1511 | 0.0588 | 0.0801 | 0.0771 | 0.0528 | 0.13 | 0.2185 |
| Cytoplasmic Foci | 0.0275 | 0.0037 | 0.015 | 0.0089 | 0.0226 | 0.0126 | 0.0173 | 0.0163 | 0.0235 | 0.0357 | 0.0769 | 0.0277 | 0.0162 | 0.0167 | 0.0182 | 0.0034 | 0.0373 | 0.0332 |
| Eisosomes | 0.0002 | 0.0001 | 0.0003 | 0.0001 | 0.0005 | 0.0001 | 0.0009 | 0.0006 | 0.0007 | 0.0004 | 0.0001 | 0.0001 | 0.0014 | 0.0007 | 0.0005 | 0.0001 | 0.0003 | 0.0001 |
| Endoplasmic Reticulum | 0.0025 | 0.0011 | 0.0014 | 0.0012 | 0.0031 | 0.0011 | 0.0131 | 0.0011 | 0.0011 | 0.0004 | 0.0016 | 0.0016 | 0.0042 | 0.0018 | 0.0015 | 0.0003 | 0.0046 | 0.0016 |
| Endosome | 0.0362 | 0.0051 | 0.0172 | 0.0018 | 0.0203 | 0.0172 | 0.0451 | 0.0049 | 0.0244 | 0.0127 | 0.0254 | 0.0148 | 0.0447 | 0.0067 | 0.0138 | 0.0004 | 0.0457 | 0.0315 |
| Golgi | 0.0067 | 0.0001 | 0.011 | 0.0001 | 0.0095 | 0.0059 | 0.0047 | 0.0034 | 0.0088 | 0.0107 | 0.0111 | 0.0015 | 0.0115 | 0.0003 | 0.0087 | 0 | 0.0344 | 0.0003 |
| Lipid Particles | 0.0399 | 0.0004 | 0.0112 | 0.0006 | 0.0068 | 0.0087 | 0.0145 | 0.0014 | 0.0054 | 0.0144 | 0.0428 | 0.0018 | 0.0207 | 0.0086 | 0.0049 | 0.0001 | 0.0152 | 0.0025 |
| Mitochondria | 0.0067 | 0.0003 | 0.0144 | 0.0008 | 0.0064 | 0.0034 | 0.0126 | 0.0062 | 0.016 | 0.0271 | 0.0069 | 0.0035 | 0.0064 | 0.0015 | 0.0137 | 0.0003 | 0.0106 | 0.0008 |
| None | 0.8041 | 0.9082 | 0.8107 | 0.9295 | 0.6688 | 0.8065 | 0.7916 | 0.8951 | 0.7837 | 0.7992 | 0.7815 | 0.7494 | 0.7317 | 0.8362 | 0.7762 | 0.9389 | 0.6826 | 0.6533 |
| Nuclear Periphery | 0.0033 | 0.001 | 0.0009 | 0.0009 | 0.0035 | 0.001 | 0.0214 | 0.0003 | 0.0009 | 0.0001 | 0.0018 | 0.0013 | 0.0067 | 0.0009 | 0.0007 | 0.0002 | 0.0032 | 0.0016 |
| Nucleolus | 0.0013 | 0.0001 | 0.0015 | 0.0005 | 0.0009 | 0.0001 | 0.0014 | 0.001 | 0.0004 | 0.0008 | 0.0005 | 0.0004 | 0.0037 | 0.0052 | 0.0007 | 0.0001 | 0.0005 | 0.0006 |
| Nucleus | 0.0058 | 0.0005 | 0.0019 | 0.0011 | 0.0078 | 0.0004 | 0.0046 | 0.0009 | 0.0018 | 0.0003 | 0.0005 | 0.0016 | 0.0064 | 0.0026 | 0.0008 | 0.0002 | 0.0025 | 0.0021 |
| Peroxisomes | 0.0089 | 0.0001 | 0.007 | 0.0002 | 0.0037 | 0.0012 | 0.011 | 0.0015 | 0.0129 | 0.027 | 0.0069 | 0.0006 | 0.0087 | 0.0005 | 0.0068 | 0.0001 | 0.0024 | 0.0015 |
| Punctate Nuclear | 0.0053 | 0.0002 | 0.002 | 0.0016 | 0.0029 | 0.0004 | 0.0028 | 0.0017 | 0.0062 | 0.0005 | 0.0044 | 0.0029 | 0.0027 | 0.0043 | 0.0009 | 0.0002 | 0.006 | 0.001 |
| Vacuole | 0.0027 | 0.005 | 0.0068 | 0.0024 | 0.0127 | 0.0022 | 0.0093 | 0.002 | 0.0111 | 0.0021 | 0.0019 | 0.0321 | 0.0173 | 0.0113 | 0.0194 | 0.0008 | 0.0112 | 0.0451 |
| Vacuole Periphery | 0.001 | 0.0004 | 0.0007 | 0.0005 | 0.0036 | 0.0005 | 0.0044 | 0.0003 | 0.0014 | 0.0005 | 0.0012 | 0.004 | 0.0023 | 0.0008 | 0.0011 | 0.0001 | 0.0014 | 0.0043 |
Sequencing Data
| R1 | R2 | |||||||||
|---|---|---|---|---|---|---|---|---|---|---|
| G1 Post-START | S/G2 | Metaphase | Anaphase | Telophase | G1 Post-START | S/G2 | Metaphase | Anaphase | Telophase | |
| Gene Expression | 4.9524 | 4.7223 | 3.5042 | 5.4282 | 4.2807 | 7.9195 | 6.1176 | 7.2509 | 7.7801 | 6.5649 |
| Translational Efficiency | 0.8294 | 0.6113 | 0.7788 | 0.5343 | 0.6276 | 0.398 | 0.4641 | 0.3128 | 0.3979 | 0.4165 |
Hit Data
| Dataset | Hit |
|---|---|
| Protein Concentration | ✘ |
| Protein Localization | ✘ |
| Gene Expression | ✘ |
| Translational Efficiency | ✘ |
Endocytosis
| Temp | Actin Patch (Sac6-tdTomato) | Cortical Patch (Sla1-GFP) | Late Endosome (Snf7-GFP) | Vacuole (Vph1-GFP) |
|---|---|---|---|---|
| 37℃ | ||||
| RT |
Cell Cycle Omics
CYCLoPs (Ydr131c-GFP)
| Gene / Allele | Actin Patch (Sac6-tdTomato) | Cortical Patch (Sla1-GFP) | Late Endosome (Snf7-GFP) | Vacuole (Sac6-tdTomato) |
|---|
| Gene | Images |
|---|
| Gene | Images |
|---|
Images are not yet available
Images are not yet available